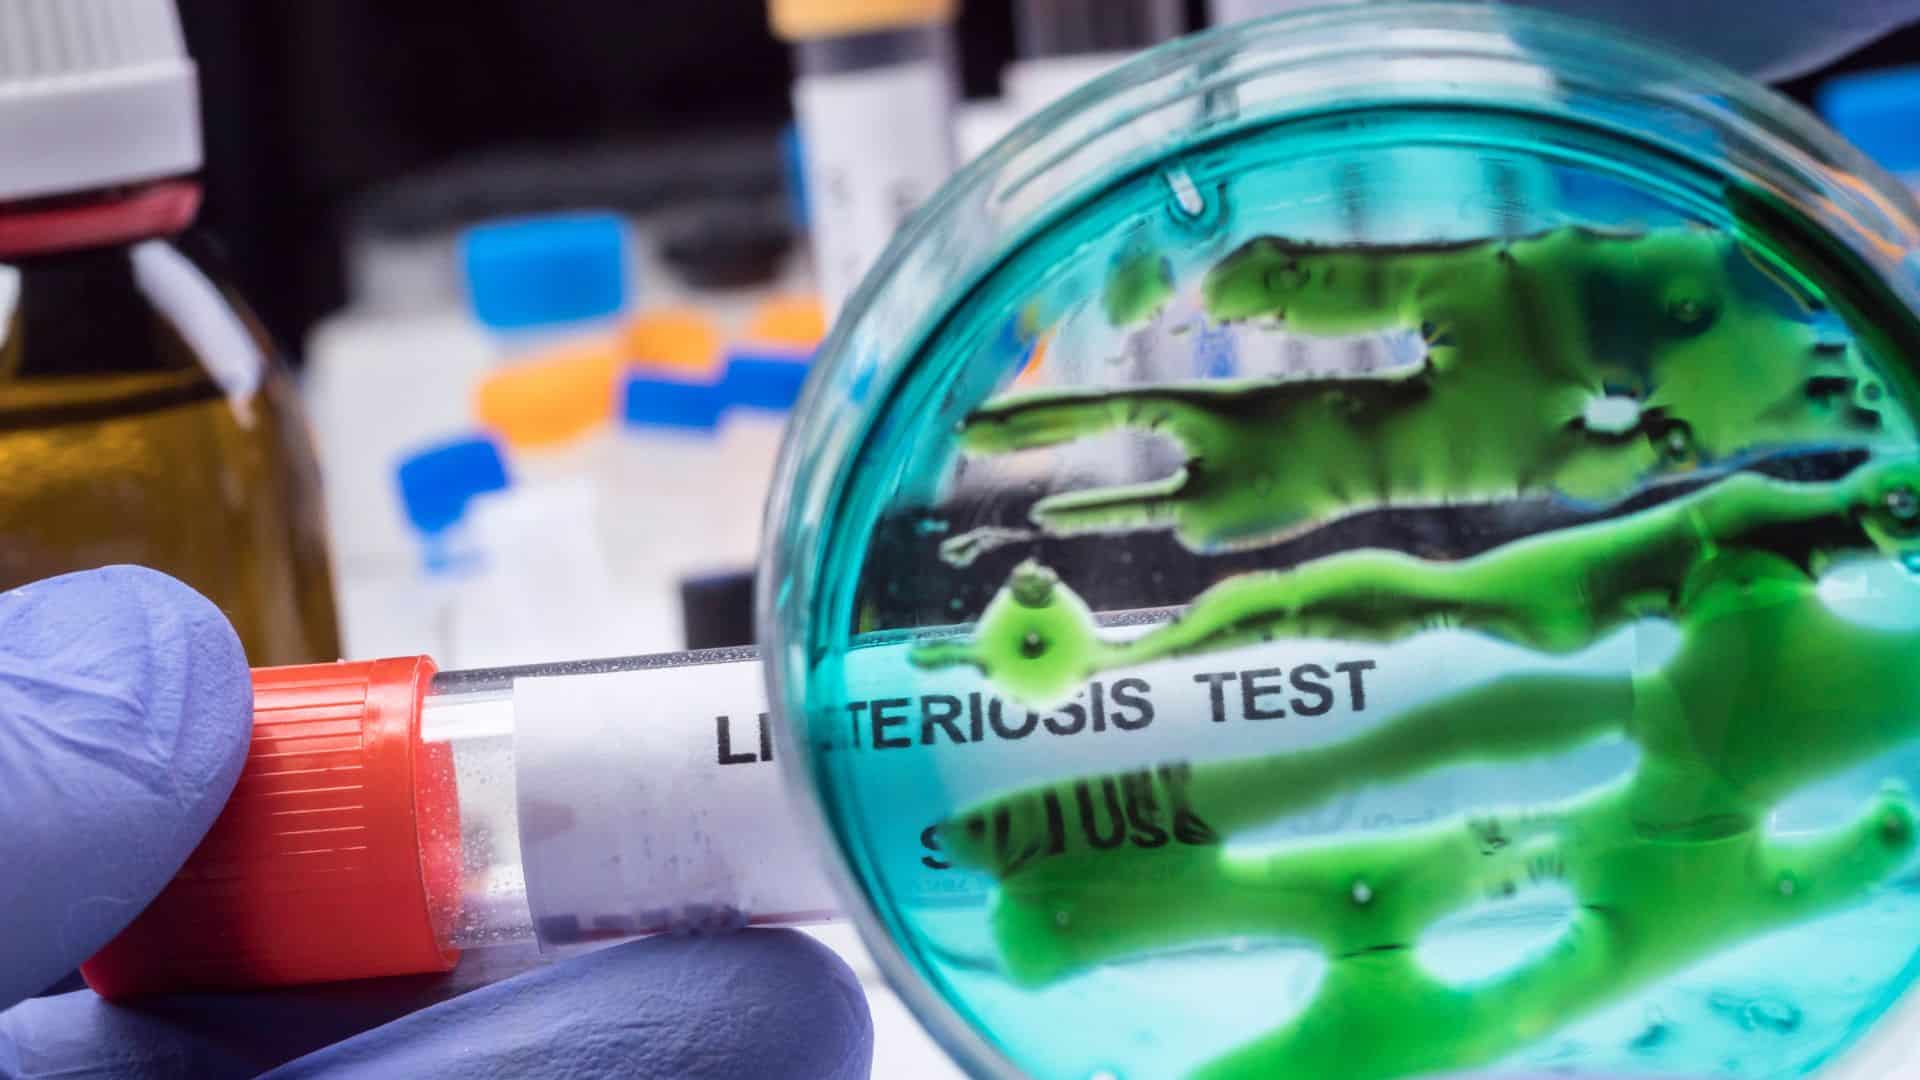

A recent public health advisory has brought attention to a Trader Joe’s ready-to-eat turkey wrap that may pose a bacterial contamination risk. Authorities are cautioning consumers about the potential presence of harmful bacteria, urging careful handling and disposal.
The Product at Issue

The alert concerns the Trader Joe’s Turkey Gobbler Wrap, packaged in 10-ounce clear clamshells. These wraps were produced on September 10 and shipped to stores nationwide, making them widely accessible to customers.
Expired but Possibly Present

Although the wrap’s “best by” date was September 16, there is a possibility that some units remain in home refrigerators. FSIS stresses that even expired products should be treated carefully to avoid potential exposure.
Public Health Alert vs. Recall

There is currently no official recall since the product is no longer on shelves. FSIS issued a public health alert to notify the public of potential risks without a formal recall in place.
Listeria Detection
Trader Joe’s reported that samples from surfaces associated with this product tested positive for Listeria monocytogenes. This finding prompted FSIS to release the alert to protect public safety.
Consumer Guidance

Anyone who purchased this wrap is advised not to consume it. FSIS recommends either discarding the product safely or returning it to the store to prevent potential infection.
How Listeria Spreads

Listeria can contaminate food during harvesting, processing, packaging, transport, or storage. Contamination often occurs in production environments where bacteria are present, according to the FDA.
Mild Listeriosis Symptoms

Non-invasive listeriosis can cause mild symptoms such as fever, muscle aches, nausea, vomiting, and diarrhea. These usually last a few days and generally affect healthy individuals only mildly.
Severe Listeriosis Risks

Invasive listeriosis occurs when bacteria spread beyond the intestines, potentially causing headaches, stiff neck, confusion, loss of balance, and convulsions. Newborns, older adults, and people with weakened immune systems face the highest risk of severe illness.
